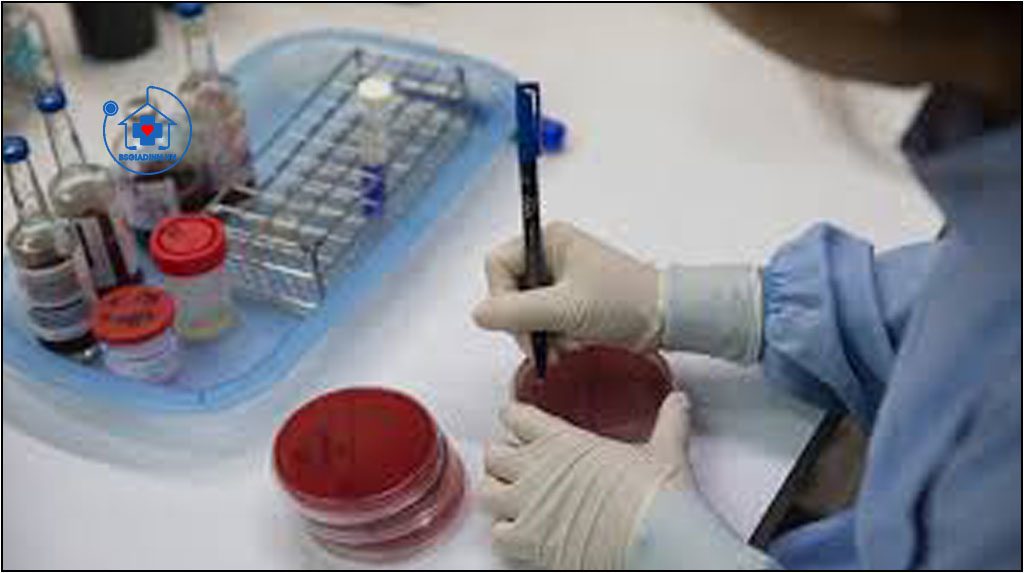

(Examen bactériologique des Selles / Stool Culture / Stool for Parasites & Bacteria)
Nhắc lại sinh lý
Bình thường ống tiêu hoá rất khó vô khuẩn do có chứa vô số các vi khuẩn hoại sinh cơ hội không mang tính chất gây bệnh. Trong một số điều kiện, vi khuẩn chí bình thường của ruột bị ức chế (Vd: do dùng kháng sinh, có tình trạng ức chế miễn dịch) các vi khuẩn còn lại có thể trở thành vi khuẩn gây bệnh. Tăng sinh của một số mầm bệnh trong ruột có thể gây viêm dạ dày, ruột, đòi hỏi phải chẩn đoán chính xác tình trạng này để tiến hành nhanh chóng điều trị đặc hiệu.
Xét nghiệm phân trực tiếp vẫn rất hữu ích đối với các thầy thuốc. xét nghiệm cho phép phát hiện:
- Các Bạch cầu (một thành phần hướng dẫn có tình trạng viêm dạ dày, ruột do nhiễm trùng).
- Các hồng cầu (định hướng chẩn đoán tới một bệnh lý khối u, loét, bệnh viêm đoạn hồi tràng Crohn, viêm đại trực tràng). Các hạt mỡ (một yếu tố chỉ dẫn giúp chẩn đoán tình trạng giảm hấp thu hay có suy tuy).
- Các ký sinh trùng (Vd: giardia lamblia, lỵ amip). cần chú ý là bệnh phẩm phải được tiến hành trên các mẫu phân tươi.
Ngoài các xét nghiệm trực tiếp, nuôi cấy phân (coproculture) là một xét nghiệm cơ bản cho phép làm chẩn đoán nguyên nhân, đôi khl cần phải tiến hành:
- Cấy ưa khí và kị khí.
- Cấy trên môi trường giàu chất dinh dưỡng.
- Tìm kí sinh trùng sau khi đã cô đặc.
- Tìm các kháng nguyên virus (Vd: rotavirus ở các trẻ nhỏ).
- Tìm độc tố vi khuẩn trên bệnh phẩm nuôi cấy mô (Vd: độc tố của clostridium difficile), nhất là ở Bệnh nhân trước đó được điều trị bằng kháng sinh.
Mục đích và chỉ định xét nghiệm
Xét nghiệm được chì định để chẩn đoán tình trạng ỉa chảy nghi vấn do nhiễm trùng.
Cách lấy bệnh phẩm
Không cần yêu cầu Bệnh nhân phải nhịn ăn trước khi lấy mẫu phân xét nghiệm.
Hầu như không có vấn đề gì do bệnh phẩm luôn hữu khuẩn, cần hướng dẫn cho bệnh nhân tránh gây nhiễm bẩn thêm bệnh phẩm và lẫn nước tiểu.
Mẩu phân tươi được lấy vào bình chứa thích hợp (không cần phải khử khuẩn) và phải được vận chuyển nhanh tới phòng xét nghiệm.
Trong trường hợp không thê gửi nhanh bệnh phẩm tới phòng xét nghiệm, cần bảo quản bệnh phầm ở nhiệt độ phòng. Bảo quản bệnh phấm trong tủ lạnh hoàn toàn không được khuyến cáo do các mầm bệnh đường ruột rất yếu và dễ bị huỷ hoại khi có thay đổi nhiệt độ.
Giá trị bình thường
Các chủng vi khuẩn chí bình thường. Không thấy có các vi khuẩn gây bệnh.
Các mầm bệnh chính gây ỉa chảy nhiễm khuẩn
A. Vi khuẩn
1. Salmonella: Có thê phân biệt vi khuân này thành các chủng typhi
và không phải là typhi.
– Salmonella typhi: Là tác nhân gây bệnh sốt thương hàn. Vi khuẩn này, mặc dù đã trở thành rất hiếm gặp ở các nước phát triển song luôn là một vi khuẩn gây nhiễm khuẩn huyết và thường gây các ổ di bệnh nhiễm khuẩn (nhất là ở não). Dường như ổ chứa tự nhiên duy nhất chỉ gặp ở người. Xác định vi khuẩn dựa trên các tiêu chuan hóa sinh và kháng nguyên (phản ứng ngưng kết bởi các kháng huyết thanh đặc hiệu).
– Salmonella không phải typhi: Là nguyên nhân gây các nhiễm salmonella với khu trú thường thấy ở ống tiêu hoá. Người bị suy giảm miễn dịch có nguy cơ cao bị nhiễm khuẩn huyết. Các kháng huyết thanh đặc hiệu cho phép phân loại các salmonella thành ba typ kháng nguyên: kháng nguyên thân (somatique = O), kháng nguyên lông (ílagellaire = H) và kháng nguyên bề mặt (Vi). Các kiếu kết hợp khác nhau của ba kháng nguyên nói trên đặc trưng cho tính đa dạng của các chủng.
2. Shigella: Vi khuẩn khu trú ở lớp dưới niêm mạc của đường tiêu hoá và là nguyên nhân gây các ỉa cháy đôi khi rất nặng. Vi khuẩn này không vào trong máu. Các typ huyết thanh tách biệt các chủng shigella khác nhau: shigella sonnei, shigella dyseníeriae, shigella flexét nghiệmeri, shigella boydii.
3. Campylobacter:
– Campylobacter fetus ít gây ia chảy mà thường gây nhiễm khuẩn huyết (chủ yếu ớ các Bệnh nhân bị suy giảm miễn dịch).
– Campylobacter laridis, coli và jejuni gây ỉa chảy kèm với phân máu và hiếm gặp hcm là tình trạng nhiễm khuẩn huyết.
4. Yersinia enterocolitica: Có thể là nguyên nhân gây ỉa chảy, hội chứng gia viêm ruột thừa, hồng ban nút và đôi khi viêm đa khớp ở người mang kháng nguyên HLA B27. Thịt lợn vừa là ổ chứa vi khuẩn đồng thời cũng là vectơ lan truyền bệnh.
5. Escherichia Coli gây bệnh
– E. Coli gây bệnh ruột (eschérichia coli pathogène): Nguyên nhân gây ỉa chay ở các nhà trẻ.
– E. Coli sinh độc tố ruột (E. Coli entérotoxinogène): Tiết một độc tố là nguyên nhân gây ỉa chảy 0 ạt có thể dẫn tới tình trạng mất nước nặng cho Bệnh nhân.
– E. Coli gây xâm nhiễm thành ruột (E.Coli enteroinvasif): Rất gần với shigella và gây ỉa chảy nặng.
6. Clostridium difficile: Là nguyên nhân gây ỉa chảy và các viêm đại tràng màng giả (colite pseudomembraneuse) chủ yếu thấy ở Bệnh nhân được điều trị bang penicillin, cephalosporin, lincomycin, clindamycin. Người ta có thể phát hiện được:
– Hoặc là Clostridium difficile trực tiếp trong phân, nhờ các môi trường chọn lọc.
– Hoặc là độc tố của Clostridium difficile bằng nuôi cấy mô.
7. Phẩy khuẩn tả: Sản xuất độc tố là nguyên nhân gây ỉa chảy và tình
trạng mất nước nặng cho bệnh nhân.
8. Vibrion parahemolytique: Nguyên nhân thường gặp gây viêm dạ
dày, ruột ở vùng Trung Đông.
B. Virus
1. Rotavirus gây các viêm ruột mùa đông nhất là ở trẻ em < 3 tuổi. Mầm bệnh này được phát hiện bằng phương pháp miền dịch trong phân (tìm kháng nguyên virus).
2. Adenovirus cũng là nguyên nhân gây viêm một ở các trẻ nhỏ.
C. Kí sinh trùng:
1. Giardia lam bia: Là một nguyên sinh động vật kí sinh ở tá tràng. Nó có thể xâm nhập vào niêm mạc một và gây các biểu hiện lâm sàng nhất là ở trẻ em và người bị suy giảm miễn dịch (ỉa chảy, đau bụng). Chẩn đoán dựa vào phát hiện được kí sinh trùng trong mẫu phân tươi, sau khi nhuộm bệnh phẩm bàng iod.
2. Lị amip (entamoeba histolytica): Là một nguyên sinh động vật kí sinh ở đại tràng, nó có thể không gây triệu chứng (người lành mang bệnh), gây ỉa chảy (bệnh lỵ amip) hoặc các biếu hiện ở xa (apxe gan, phổi, não).

Các yếu tố góp phần làm thay đối kết quả xét nghiệm
Các thuốc có thể gây kết quả âm tính giả: Sử dụng kháng sinh, barium, bismuth.
Lợi ích của xét nghiệm vi khuẩn học bệnh phẩm phân
1. xét nghiệm không thể thiếu trong thăm dò các bệnh nhân bị ỉa chảy nhất là
khi tiến hành phối hợp tìm hồng cầu, bạch cầu trong phân.
2. xét nghiệm cho phép xác định tác nhản gây bệnh cua viêm dạ dày một nhiễm trùng: Chân đoán nhiễm campylobacter, pháy khuân tả, tụ cầu, amib đôi khi có thề được xác nhận ngay sau một xét nghiệm phân trực tiếp. Phát hiện được một số vims (rotavims) khi kiếm tra bệnh phẩm phân với kính hiển vi điện tử và có thể hữu ích trong điều trị dịch tễ.
3. xét nghiệm cho phép đánh giá hiệu qủa của một điều trị kháng sinh.
Các hướng dẫn thực hành lâm sàng dựa trên y học bằng chứng
1. Các Bệnh nhân có biểu hiện ỉa chảy kéo dài quá 2 tuần sẽ có chỉ định xét nghiệm phân (bao gồm cả tìm bạch cầu trong phân, cấy phân, tìm trứng và ký sinh trùng trong phân, tìm clostridium difficile và thậm chí cả giardia).
2. Theo dõi và tiến hành xét nghiệm phân định kỳ được chỉ định khi:
- Các biểu hiện triệu chứng tiếp diễn ngay cả khi xét nghiệm ban đầu âm tính.
- Để chứng minh mầm bệnh không còn được tìm thấy trong phân nữa


